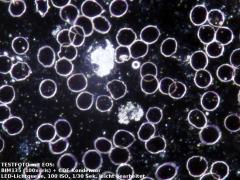

(--Lacerta hot product: CDF)
(0 JPY netto)
(Bruttopreise sind mit 19% bzw. 7% MWSt kalkuliert. Sollte die MWSt in Ihrem Land höher sein, übernimmt LACERTA GmbH die Differenz.)
zzgl. Versand
Unterkategorie: Dunkelfeld
Max.Vergr.: 1000
Versandgewicht: 1kg (Versandkosten)
Lieferbarkeit
(Der Lagerbestand dient nur zur Information und beinhaltet auch bereits reservierte Exemplare)
Wien: Wir bestellen gerne für Sie!
Linz: nur noch 2 verfügbar
Lager: nur noch 1 Stk.
Öffnungszeiten
Woanders billiger? weiter...
| Wir empfehlen auch: | ||
|---|---|---|
|
Aplan10... 449.90 EUR |

|
|
|
I-plan60x 219.90 EUR |

|
|
|
LIS-5 1599.90 EUR |

|
|
|
Aplan60x 169.90 EUR |

|
|
Lebendblut Analyse im Dunkelfeld
Dieses Nachrüstpaket für Hellfeldmikroskope passt an alle Kondensorhalterungen mit 37mm Steckduchmesser. Wir bieten auch Speziallösungen für Ihr eigenes Mikroskope an (Zeiss Primostar, Lacerta Infinity und Maxutov XSP-251 Adaptionen sind bereits vorhanden). Fragen Sie uns!
Adaptation an Mikroskope
Ihr Mikroskop muss nur zwei Bedingungen erfüllen, damit es zum vollwertigen Dunkelfeldmikroskop umgebaut werden kann:
- Austauschbarer Kondensor mit 37mm Steckdurchmesser (das ist Standard) oder per Schwalbenschwanz zu befestigen (Lacerta, Zeiss, Maxutov)
- Verstellbare Kondensorhalterung (in der Höhe, aber auch seitlich in der Kreuztischebene muss eine Zentriermöglichkeit vorhanden sein)
Leicht nachzurüsten!
Das Verfahren heißt CDF (Cardioid Dark Field) und hier in diesem Video erklären wir, wie leicht es nachzurüsten ist:


(das Video zeigt noch ein früheres CDF Kondensor Modell. Seit 2020 haben die CDF Kondensoren einen wesentlich kompakten Aufbau)
Unsere CDF Einheit mit LED Beleuchtung wird in Ungarn hergestellt und in Österreich zusammengebaut. Der Cardioid-Kondensor hat eine integrierte Hochleistungs LED Beleuchtung, welche ca. 150W an Halogenbeleuchtung entspricht. Die LED arbeitet mit niedriger Spannung (5V bis 12V, auch USB Adapter reicht).
Lieferumfang
- CDF Cardioid Kondensor mit eingebauter LED Lichtquelle und Dimmer
- 220V / 12V AC/DC Adapter (1A)
F.A.Q.:
-
Was ist der Unterschied zwischen Dunkelfeld und Cardioid Dunkelfeld? In der Dunkelfeld-Mikroskopie ALLGEMEIN, findet meistens ein
Abbe-Kondensor mit Zentralblende (z.B.: N.A. 0,4-0,65) Verwendung.
Dunkelfeldkondensoren mit Zentralblende reichen für
Dunkelfeldbeleuchtung bis zu einem 20x oder 40x Objektiv (bis N.A.=0,4). Das sind
sogenannte trockene Kondensoren (dry) und sind ohne Immersionsöl zu
verwenden. Für höhere Auflösung und Vergrößerung ist ein Cardioid
Kondensor und Objektive mit mindestens 60x Vergrößerung (um etwa N.A.=0,8) nötig. Das sind
Ölimmersions-Kondensoren (oil), das bedeutet auch zwischen Objektträger und
Kondensor gehört ein Tropfen Immersionsöl.
- Warum wird eine Irisblende in dem 100x Objektiv benötigt? Um unerwünschte Reflexionen zu unterdrücken muss die nummerische Apertur bis zu ca. 0,8 verringert werden. Ohne Irisblende (mit höherem Numerischen Apertur) erhöht sich das defokussierte Hintergrundlicht und vermindert den Kontrast: Ein Schleier liegt über dem Bild.
- Gibt es eine alternative Empfehlung was das Objektiv betrifft, zum Beispiel ohne Irisblende? Ja. Alle Objektive mit 0,8 numerischer Apertur (z.B. die meiste 60x-er Planachromaten) können direkt, ohne Irisblende verwendet werden. Diese Lösung hat das Vorteil, dass der Präparat von oben kein Immersionsöl mehr braucht und das Objektiv muss nicht vom Öl gereinigt werden.
- Wie viel Licht braucht man für die Lebendblutuntersuchung? Als Faustregel gilt als Minimum 100W Kaltlicht oder eine äquivalente Lichtmenge. Dies konnte früher nur mit einer externen Kaltlichtquelle und Lichtleiter erreicht werden. Mit dem neuen CDF-System entsteht die gleiche Lichtleistung, jedoch preiswerter und platzsparender. Auch die Bedienung (Zusammenbau, Justage usw...) ist einfacher und schneller.
- Was bedeutet eigentlich Cardioid? Bei hohen Vergrößerungen kommt in der Dunkelfeld-Mikroskopie statt einem Abbe-Kondensor mit Zentralblende (trockener Dunkelfeldkondensor, welcher ca. 5-10% Lichtausbeute hat und ohne Immersionsöl verwendbar ist) ein verspiegeltes und verkittetes Linsensystem von zwei Linsen und zwei verspiegelten Flächen zur Anwendung, der Cardioid Condensor. Die Lichtausbeute beträgt deutlich über 75%, aber seine hervorragenden optischen Eigenschaften werden nur mit einem Tropfen Immersionsöl zwischen dem Kondensor und Objektträger (d.h. von unten ölen!) erreicht.
- Wird der Cardioid Dunkelfeld Kondensor nicht zu heiss? Nein und Nein. Erstens, weil LEDs wesentlich weniger Hitze erzeugen als eine Halogen Lichtquelle. Zweitens, weil der CDF Corpus eine passive Kühlung besitzt. Wir haben in unserem Shop gemessen, dass die Temperatur von CDF-Kondensoren auch nach stundenlangem Betrieb nicht über 36 Grad steigt.
- Welche Mikroskope können mit Cardioid-Dunkelfeld nachgerüstet werden? Die Mindestanforderung an ein Mikroskop um es mit Cardioid-Dunkelfeld nachzurüsten, ist lediglich ein austauschbarer Kondensor mit justierbarer Kondensorhalterung. Nicht notwendig, jedoch empfehlenswert ist eine halbwegs hochwertige mechanische Qualität des Mikroskops, damit die optischen Elemente sich feinfühlig einstellen lassen und sich während der Untersuchung auch nicht verstellen. Alle Cardioid-Systeme sind sehr empfindlich hinsichtlich der richtigen Einstellung. Falsche Abstände, alle Dezentrierungen oder Verkippungen beeinträchtigen die optische Qualität!
- Wie funktioniert Dunkelfeld? Das Dunkelfeld-Verfahren allgemein basiert auf dem gleichen Prinzip, das schwebende Staubpartikel sichtbar werden lässt wenn Licht durch einen kleinen Spalt in einen dunklen Raum fällt (z.B. Sonnenlicht durchs Kellerfenster). Direktes Licht von der Lichtquelle erreicht dabei nicht das Mikroskopobjektiv, sondern nur jenes welches am Präparat gestreut wird - der Hintergrund ist deshalb dunkel. Das Verfahren wurde erstmals von Robert Andrews Millikan verwendet, um im elektromagnetischen Feld schwebende Öltropfen zu untersuchen. Später - 1923 - hat Millikan unter anderem für seine berühmten Öltropfen-Experimente den Nobelpreis für Physik erhalten.
- Wie kann ich den CDF-Kondensor an meinem Mikroskop anpassen? Die Bauhöhe des CDF-Kondensors kann in einem weitem Bereich eingestellt werden. Dafür wird nur ein 2mm Inbusschlüssel benötigt. Erst löst man die beiden 4mm langen M4 Madenschrauben (siehe drittes Bild über den Produktpräsentation). Dann kann das mittlere Teil samt Cardioid Optik aufwärts oder abwarts verstellt werden. Stellen sie die Höhe so ein, dass der CDF Kondensor den Objekttrager gerade noch nicht berührt. Danach ziehen Sie die beiden M4 Schrauben sehr vorsichtig und nur leicht an (nur um gegen versehentliches Verstellen zu fixieren). Diese Einstellung muss nur einmal am Anfang gemacht werden.
Frühere Modelle
Einen Cardioid Kondensor ohne eingebaute Lichtquelle bieten wir nicht
mehr an. Betrachten Sie die Testfotos selbst und sehen Sie den
Unterschied:
- Testfoto mit eingebauter LED Lichtquelle mit kurzer 1/30 sek Expositionszeit bei 100 ISO
- Testfoto mit orginal Mikroskopbeleuchtung mit lange 1 sek Expositionszeit bei 800 ISO
#Dunkelfeldmikroskopie #szn
 |
Aplan100x-iris | 100x Planobjektiv für Dunkelfeldmikroskopie mit Irisblende (Universal verwendbar, sowohl für 160mm als auch für Infinity Tuben) | 449.90 EUR | |
 |
I-plan60x | Planobjektiv (60x, infinity) für LACERTA Infinity Series (LIS) | 219.90 EUR | |
 |
LIS-5 | LIS-5 Mikroskop, mit 4 PLAN Objektiven (4x, 10x, 40x, 100x) mit Fototubus und Full Köhler Beleuchtung | 1599.90 EUR | |
 |
Aplan60x | Planobjektiv (60x, 160mm) | 169.90 EUR |
WELCHES TELESKOP SOLL ICH KAUFEN?
Fragen Sie uns - Kontakt
Unser Shop in WIEN
Unser Shop in LINZ
Adresse und Öffnungszeiten
Zahlung und Versand
Vor dem Kauf (Ratgeber)
Rücksendungs-Formular
astronomieforum.at
astronomie.de
mikroskopie-forum.at
bird.at Forum
Links und Partners
Veranstaltungen (Kalendarium)
Firmendaten
Allgemeine Geschäftsbedingungen (AGB)
Haftungsausschluss
Urheberrecht (Copyright)
Widerrufsbelehrung
© 2005-2026 Lacerta GmbH.
All rights reserved.

 Zahlung und Versand
Zahlung und Versand